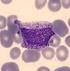
Correlazione tra ADVIA e striscio manuale

PROGRAMMA VEQ MORFOLOGIA CELLULARE CICLO 2015
|
|
|
- Geraldo Amato
- 9 anni fa
- Просмотров:
Транскрипт
1 PROGRAMMA VEQ MORFOLOGIA CELLULARE CICLO 2015 Alessandra Fanelli Firenze 24 ottobre 2016 Laboratorio Generale Dipartimento dei Servizi
2 CICLO 2015 ESAME MORFOLOGICO SU STRISCIO DI SANGUE PERIFERICO CAMPIONE 1 CAMPIONE 2 CAMPIONE 4 CAMPIONE 6 MORFOLOGIA DIGITALE CAMPIONE 3 CAMPIONE 5
3 ESAME MORFOLOGICO SU STRISCIO DI SANGUE PERIFERICO CAMPIONE 1 Diagnosi clinica : Eosinofilia reattiva a parassitosi Esame emocromocitometrico: nella norma Anomalie morfologiche target: - senza anomalie leucocitarie (1) - senza anomalie eritrocitarie (1) - aggregati piastrinici (score 0,5) - piastrine giganti (score 0,5)
4
5 ESAME MORFOLOGICO SU STRISCIO DI SANGUE PERIFERICO CAMPIONE 2 Diagnosi clinica: mononucleosi infettiva Esame emocromocitometrico: nella norma Anomalie morfologiche target: - cellule linfoidi iperbasofile (score 2) - linfociti atipici (score 1)
6
7 MORFOLOGIA DIGITALE CAMPIONE 3 Diagnosi clinica: leucemia a cellule capellute Esame emocromocitometrico: leucocitosi Anomalie morfologiche target: - tricoleucociti (score 1) - linfociti atipici (score 0,5) - anisopoichilocitosi (score 0,5)
8
9
10
11 ESAME MORFOLOGICO SU STRISCIO DI SANGUE PERIFERICO CAMPIONE 4 Diagnosi clinica: leucemia a cellule capellute Esame emocromocitometrico: leucocitosi anisopoichilocitosi (RDW 16%) Anomalie morfologiche target: - tricoleucociti (score 1) - linfociti atipici (score 1) - anisopoichilocitosi (score 0,5) - senza anomalie piastriniche (0,5)
12
13 MORFOLOGIA DIGITALE CAMPIONE 5 Diagnosi clinica: mielodisplasia Esame emocromocitometrico: leucocitosi, anemia, piastrinopenia Anomalie morfologiche target: - displasia granulocitaria (score 1) - schistociti (score 1) - piastrine giganti (score 1)
14
15
16
17 MORFOLOGIA DIGITALE CAMPIONE 6 Diagnosi clinica: anemia a cellule falciformi Esame emocromocitometrico: anemia, leucopenia Anomalie morfologiche target: - drepanociti (score 2) - schistociti (score 1) - anisopoichilocitosi (score 0,5) - anisocromia (score 0,5)
18
19 L armonizzazione ha come obiettivo finale il miglioramento degli esiti del paziente attraverso la produzione di informazioni di laboratorio accurate e fruibili. I risultati di esami clinici eseguiti da laboratori diversi sullo stesso campione devono poter essere confrontati con affidabilità e coerente interpretazione
20 REFERTO EMATOLOGICO CON UNITA DI MISURA CONFORMI AL SISTEMA INTERNAZIONALE: NECESSITA DI ARMONIZZAZIONE A. Papa, S. Buoro, A. Marini, F. Balboni, A. Fanelli, G. Da Rin, AM. Di Fabio, S. Francione, M. Gioia, S. Pipitone, D. Tanca, F. Fiorini, V. Rocco, F. Cocci, A. La Gioia Gruppo di Studio di Diagnostica Ematologica SiBioC 2015
21 ARMONIZZAZIONE DELLA DIAGNOSTICA EMATOLOGICA: LO STATO DELLA VALUTAZIONE DEI RETICOLOCITI E. Piva, S. Secchiano, F. Spolaore, F. Tosato, M. Plebani 2016
22 BACKGROUND I conteggi reticolocitari automatizzati pur essendo indiscutibilmente vantaggiosi rispetto al metodo microscopico per la maggiore riproducibilità e la riduzione dei tempi di risposta, presentano ancora molto variabilità e scarsa armonizzazione soprattutto per i parametri di maturità e gli indici. Problematiche aperte: 1) vasta gamma di reagenti 2) diversa affinità di legame per l RNA 3) differenti tecnologie (fluorescenza, assorbanza, light-scattering) 4) diversi software per l analisi dei segnali 5) mancanza di materiali di riferimento 6) mancanza di armonizzazione sugli indici di immaturità
23 SCOPO DELLO STUDIO Comparare in una casistica selezionata l analisi dei reticolociti con 3 analizzatori ematologici di ultima generazione e di valutare il grado di armonizzazione dei metodi integrando lo studio con l analisi retrospettiva dei dati del programma VEQ per reticolociti
24 82 campioni
25
26
27
28 Intervalli di riferimento Reticolociti in assoluto IRF
29 INTERVALLI DI RIFERIMENTO (IR) Reticolociti # 21 IR diversi in 41 laboratori partecipanti alla VEQ Gli IR adottati dagli utilizzatori dei sistemi Siemens Advia complessivamente presentano un limite superiore più elevato rispetto agli IR di altri sistemi IRF 11 IR diversi in 15 laboratori partecipanti alla VEQ
30 CONCLUSIONI Ottima concordanza tra i 3 analizzatori di ultima generazione nell intervallo di valori esplorato per i conteggi reticolocitari Non sono stati raggiunti ancora livelli soddisfacenti di standardizzazione ed efficienza diagnostica per il parametro IRF che presenta sia variabilità di misura fra tecnologie differenti, sia variabilità degli Intervalli di Riferimento tra laboratori che utilizzano gli stessi contaglobuli Il contenuto di emoglobina reticolocitario è determinato con due metodiche fondamentalmente diverse con conseguente mancanza di intercambiabilità fra e scarsa correlazione analoga variabilità metodologia/analitica per il volume cellulare medio reticolocitario La marcata variabilità degli IR può potenzialmente determinare un differente giudizio e interpretazione clinica e causare conseguentemente un diverso approccio clinico o terapeutico
PROGRAMMA VEQ MORFOLOGIA CELLULARE CICLO 2016
 PROGRAMMA VEQ MORFOLOGIA CELLULARE CICLO 2016 Alessandra Fanelli Firenze 15 maggio 2017 Laboratorio Generale Dipartimento dei Servizi CICLO 2016 ESAME MORFOLOGICO SU STRISCIO DI SANGUE PERIFERICO CAMPIONE
PROGRAMMA VEQ MORFOLOGIA CELLULARE CICLO 2016 Alessandra Fanelli Firenze 15 maggio 2017 Laboratorio Generale Dipartimento dei Servizi CICLO 2016 ESAME MORFOLOGICO SU STRISCIO DI SANGUE PERIFERICO CAMPIONE
ESAMI EMATOCHIMICI E ESAMI STRUMENTALI IN EMATOLOGIA
 ESAMI EMATOCHIMICI E ESAMI STRUMENTALI IN EMATOLOGIA ESAMI EMATOCHIMICI e STRUMENTALI esame emocromocitometrico completo formula leucocitaria conta dei reticolociti striscio di sangue periferico esami
ESAMI EMATOCHIMICI E ESAMI STRUMENTALI IN EMATOLOGIA ESAMI EMATOCHIMICI e STRUMENTALI esame emocromocitometrico completo formula leucocitaria conta dei reticolociti striscio di sangue periferico esami
Con Il patrocinio di ASL Salerno-AORN G. Rummo Benevento. SIBioC SIMeL
 SCUOLA DI FORMAZIONE IN EMATOLOGIA I Edizione Con Il patrocinio di ASL Salerno-AORN G. Rummo Benevento SIBioC SIMeL Professioni interessate: MEDICI E BIOLOGI Sede del Corso: Aula Magna Presidio Ospedaliero
SCUOLA DI FORMAZIONE IN EMATOLOGIA I Edizione Con Il patrocinio di ASL Salerno-AORN G. Rummo Benevento SIBioC SIMeL Professioni interessate: MEDICI E BIOLOGI Sede del Corso: Aula Magna Presidio Ospedaliero
L esame emocromocitometrico in pediatria Principi generali e valori di normalità
 FIMPAGGIORNA 2005 12 maggio 2005 L esame emocromocitometrico in pediatria Principi generali e valori di normalità Luciano Pinto Dipartimento di Pediatria A.O.R.N. Santobono-Pausilipon Ma come è pallido.
FIMPAGGIORNA 2005 12 maggio 2005 L esame emocromocitometrico in pediatria Principi generali e valori di normalità Luciano Pinto Dipartimento di Pediatria A.O.R.N. Santobono-Pausilipon Ma come è pallido.
PREMESSE *****************
 OGGETTO: Capitolato per la fornitura omnicomprensiva di sistemi completi di diagnostica per l effettuazione in routine e urgenza dell esame emocromocitometrico per la Struttura Complessa Laboratorio Analisi
OGGETTO: Capitolato per la fornitura omnicomprensiva di sistemi completi di diagnostica per l effettuazione in routine e urgenza dell esame emocromocitometrico per la Struttura Complessa Laboratorio Analisi
Analisi morfologica del sangue periferico
 Analisi morfologica del sangue periferico Giuseppe d Onofrio Università Cattolica del Sacro Cuore, Roma Struttura del corso 1. Linfociti e patologie linfoproliferative 2. Granulociti e neoplasie mieloproliferative
Analisi morfologica del sangue periferico Giuseppe d Onofrio Università Cattolica del Sacro Cuore, Roma Struttura del corso 1. Linfociti e patologie linfoproliferative 2. Granulociti e neoplasie mieloproliferative
Formazione Interdisciplinare sulla valutazione analitica-clinica in Corelab Emocromocitometrico
 Formazione Interdisciplinare sulla valutazione analitica-clinica in Corelab Emocromocitometrico Dott.ssa L. Arrigoni - 2014 Il Passato Conta cellule, reticolociti e piastrine manuale Hb spettrofotometrica
Formazione Interdisciplinare sulla valutazione analitica-clinica in Corelab Emocromocitometrico Dott.ssa L. Arrigoni - 2014 Il Passato Conta cellule, reticolociti e piastrine manuale Hb spettrofotometrica
AGGIORNAMENTI IN EMATOLOGIA DIAGNOSTICA: LA VALUTAZIONE MICROSCOPICA NORMALE E PATOLOGICA
 Società Italiana di Biochimica Clinica e Biologia Molecolare Clinica SIBioC utlizza un Sistema di Gestione Qualità certificato ISO 9001:2000 per progettazione ed erogazione di eventi formativi con il patrocinio
Società Italiana di Biochimica Clinica e Biologia Molecolare Clinica SIBioC utlizza un Sistema di Gestione Qualità certificato ISO 9001:2000 per progettazione ed erogazione di eventi formativi con il patrocinio
REGISTRO DELLE LEZIONI 2005/2006. Tipologia. Addì Tipologia. Addì Tipologia. Addì
 Strumentazione di laboratorio:dotazione minima, principi di funzionamento. di referenza e certificazione di qualità. Accuratezza e precisione dei risultati. pratica con il contaglobuli ad impedenza elettrica/laser
Strumentazione di laboratorio:dotazione minima, principi di funzionamento. di referenza e certificazione di qualità. Accuratezza e precisione dei risultati. pratica con il contaglobuli ad impedenza elettrica/laser
FISIOPATOLOGIA DEL SANGUE: ESAME EMOCROMOCITOMETRICO
 FISIOPATOLOGIA DEL SANGUE: ESAME EMOCROMOCITOMETRICO Dr.ssa Marta Greco Scienze Infermieristiche Il sangue è un tessuto fluido costituito da cellule sospese nella parte liquida (plasma) attraverso il quale
FISIOPATOLOGIA DEL SANGUE: ESAME EMOCROMOCITOMETRICO Dr.ssa Marta Greco Scienze Infermieristiche Il sangue è un tessuto fluido costituito da cellule sospese nella parte liquida (plasma) attraverso il quale
Striscio di formazione HD
 Febbraio 2012 Striscio di formazione 11-11-HD Ha ricevuto gratuitamente, con l inchiesta 11-11-HD, uno striscio supplementare di formazione. Trova qui sotto il commento dell esperto, il Dott. Keller dell
Febbraio 2012 Striscio di formazione 11-11-HD Ha ricevuto gratuitamente, con l inchiesta 11-11-HD, uno striscio supplementare di formazione. Trova qui sotto il commento dell esperto, il Dott. Keller dell
Prof AM Vannucchi AA2009 10
 LEUCEMIE ACUTE 1 DEFINIZIONE Leucemia Acuta Sangue bianco decorso rapido, aggressivo Malattia clonale a carico dei progenitori emopoietici caratterizzata da alterate differenziazione e proliferazione con
LEUCEMIE ACUTE 1 DEFINIZIONE Leucemia Acuta Sangue bianco decorso rapido, aggressivo Malattia clonale a carico dei progenitori emopoietici caratterizzata da alterate differenziazione e proliferazione con
Written by Tuesday, 12 August :26 - Last Updated Sunday, 21 November :45
 Anemia Aplastica acquisita Rara malattia ematologia, non oncologica Sua caratteristica è una netta riduzione di globuli bianchi, rossi e piastrine nel sangue (pancitopenia periferica) a volte gravissima
Anemia Aplastica acquisita Rara malattia ematologia, non oncologica Sua caratteristica è una netta riduzione di globuli bianchi, rossi e piastrine nel sangue (pancitopenia periferica) a volte gravissima
Nuove Opportunità Tecnologiche in Diagnostica Ematologica
 Nuove Opportunità Tecnologiche in Diagnostica Ematologica Pisa, CO.ME.LAB. 2014 [email protected] Quali opportunità tecnologiche? I N F O R M A Z I O N E C L I N I C A Opportunità Organizzative Opportunità
Nuove Opportunità Tecnologiche in Diagnostica Ematologica Pisa, CO.ME.LAB. 2014 [email protected] Quali opportunità tecnologiche? I N F O R M A Z I O N E C L I N I C A Opportunità Organizzative Opportunità
I TUMORI EMATOLOGICI schede operative
 XV Corso di aggiornamento per operatori dei Registri Tumori Modena, 6-8 ottobre 2015 I TUMORI EMATOLOGICI schede operative Francesca Roncaglia Registro Tumori Reggio Emilia Sommario - razionale del progetto
XV Corso di aggiornamento per operatori dei Registri Tumori Modena, 6-8 ottobre 2015 I TUMORI EMATOLOGICI schede operative Francesca Roncaglia Registro Tumori Reggio Emilia Sommario - razionale del progetto
Correlazione tra ADVIA e striscio manuale
Scuola Superiore Medico-Tecnica Locarno Formazione tecnico in analisi biomediche Lavoro di Stage Correlazione tra ADVIA e striscio manuale Lavoro di stage di Patrick Carinci TAB2 ANNO 2012 Sommario Introduzione...
Scuola Superiore Medico-Tecnica Locarno Formazione tecnico in analisi biomediche Lavoro di Stage Correlazione tra ADVIA e striscio manuale Lavoro di stage di Patrick Carinci TAB2 ANNO 2012 Sommario Introduzione...
FISIOPATOLOGIA DEL SANGUE: ESAME EMOCROMOCITOMETRICO
 FISIOPATOLOGIA DEL SANGUE: ESAME EMOCROMOCITOMETRICO Dr.ssa Marta Greco Scienze Infermieristiche Il sangue è un tessuto fluido costituito da cellule sospese nella parte liquida (plasma) attraverso il quale
FISIOPATOLOGIA DEL SANGUE: ESAME EMOCROMOCITOMETRICO Dr.ssa Marta Greco Scienze Infermieristiche Il sangue è un tessuto fluido costituito da cellule sospese nella parte liquida (plasma) attraverso il quale
FISIOPATOLOGIA DEL SANGUE: ESAME EMOCROMOCITOMETRICO
 FISIOPATOLOGIA DEL SANGUE: ESAME EMOCROMOCITOMETRICO Dr.ssa Marta Greco Scienze Infermieristiche Il sangue è un tessuto fluido costituito da cellule sospese nella parte liquida (plasma) attraverso il quale
FISIOPATOLOGIA DEL SANGUE: ESAME EMOCROMOCITOMETRICO Dr.ssa Marta Greco Scienze Infermieristiche Il sangue è un tessuto fluido costituito da cellule sospese nella parte liquida (plasma) attraverso il quale
Laboratorio Analisi Guidonia
 Laboratorio Analisi Guidonia Analisi Chimico Cliniche - Microbiologiche - pap test - RIA Via Roma, 190A - 00012 Guidonia - Tel. 0774.345000 - Fax: 0774.341095 Rif. Acc. N. 130 del 27.08.2016 PROIETTI MARCHETTI
Laboratorio Analisi Guidonia Analisi Chimico Cliniche - Microbiologiche - pap test - RIA Via Roma, 190A - 00012 Guidonia - Tel. 0774.345000 - Fax: 0774.341095 Rif. Acc. N. 130 del 27.08.2016 PROIETTI MARCHETTI
ESAME CHIMICO FISICO DELLE URINE E DEL SEDIMENTO per i presidi di Pescara, Penne, Popoli.
 SPECIFICHE TECNICHE DEI SISTEMI DIAGNOSTICI PER L ESECUZIONE DELL ESAME CHIMICO FISICO DELLE URINE E DEL SEDIMENTO per i presidi di PESCARA, PENNE E POPOLI. LOTTO n 5 ESAME CHIMICO FISICO DELLE URINE E
SPECIFICHE TECNICHE DEI SISTEMI DIAGNOSTICI PER L ESECUZIONE DELL ESAME CHIMICO FISICO DELLE URINE E DEL SEDIMENTO per i presidi di PESCARA, PENNE E POPOLI. LOTTO n 5 ESAME CHIMICO FISICO DELLE URINE E
21 giorni. 21 giorni. 21 giorni. Disponibile per tutti i Programmi. Disponibile per tutti i programmi eccetto CELL435
 Calendario degli Esercizi 2014 Il seguente Calendario degli Esercizi fa riferimento a tutti i Programmi in questa sezione. Esercizio Inizio Esercizio Finestra d Esercizio Scadenza Inserimento 1 mercoledì,
Calendario degli Esercizi 2014 Il seguente Calendario degli Esercizi fa riferimento a tutti i Programmi in questa sezione. Esercizio Inizio Esercizio Finestra d Esercizio Scadenza Inserimento 1 mercoledì,
Scienze tecniche di Medicina di Laboratorio
 Corso di Laurea Magistrale delle Professioni Sanitarie Tecnico-Diagnostiche LM/SNT3 2 anno Scienze tecniche di Medicina di Laboratorio Argomenti della lezione Il controllo di qualità nella diagnostica
Corso di Laurea Magistrale delle Professioni Sanitarie Tecnico-Diagnostiche LM/SNT3 2 anno Scienze tecniche di Medicina di Laboratorio Argomenti della lezione Il controllo di qualità nella diagnostica
ANALISI URINE UN ESAME DI QUALITÀ AL SERVIZIO DELLA CLINICA
 ANALISI URINE UN ESAME DI QUALITÀ AL SERVIZIO DELLA CLINICA ANALISI URINE UN ESAME DI QUALITÀ AL SERVIZIO DELLA CLINICA L analisi di qualità della matrice urinaria è fondamentale per la diagnosi precoce
ANALISI URINE UN ESAME DI QUALITÀ AL SERVIZIO DELLA CLINICA ANALISI URINE UN ESAME DI QUALITÀ AL SERVIZIO DELLA CLINICA L analisi di qualità della matrice urinaria è fondamentale per la diagnosi precoce
EMATOLOGIA: LA STORIA
 EMATOLOGIA: LA STORIA 1970 Le Le medicine specialistiche si si staccano dalla medicina interna 1980 L ematologia include alcune attività di di laboratorio specialistiche 1990 Le Le tecnologie diagnostiche
EMATOLOGIA: LA STORIA 1970 Le Le medicine specialistiche si si staccano dalla medicina interna 1980 L ematologia include alcune attività di di laboratorio specialistiche 1990 Le Le tecnologie diagnostiche
VALIDAZIONE DI PARAMETRI EMATOCHIMICI E COMPORTAMENTALI IN MAMMIFERI SELVATICI MANTENUTI IN CONDIZIONI DI ALLEVAMENTO, CATTIVITÀ E A VITA LIBERA.
 VALIDAZIONE DI PARAMETRI EMATOCHIMICI E COMPORTAMENTALI IN MAMMIFERI SELVATICI MANTENUTI IN CONDIZIONI DI ALLEVAMENTO, CATTIVITÀ E A VITA LIBERA. Ricerca finanziata dal Ministero della Salute, Dipartimento
VALIDAZIONE DI PARAMETRI EMATOCHIMICI E COMPORTAMENTALI IN MAMMIFERI SELVATICI MANTENUTI IN CONDIZIONI DI ALLEVAMENTO, CATTIVITÀ E A VITA LIBERA. Ricerca finanziata dal Ministero della Salute, Dipartimento
Azienda Ospedaliero Universitaria Careggi
 Azienda Ospedaliero Universitaria Careggi Laboratorio Generale Centro Regionale di Riferimento per il Controllo di Qualità AOU Careggi - Firenze Stato dell Arte della misura della HbA 1C Anna Caldini 1
Azienda Ospedaliero Universitaria Careggi Laboratorio Generale Centro Regionale di Riferimento per il Controllo di Qualità AOU Careggi - Firenze Stato dell Arte della misura della HbA 1C Anna Caldini 1
SCHEMA DI VEQ PER VES METODO WESTERGREN. Emissione 2 25/11/2011 Approvazione DCRB Pagina 1 di 7
 Emissione 2 25/11/2011 Approvazione DCRB Pagina 1 di 7 PROGRAMMA DI VEQ PER VES A. Organizzazione del Programma MATERIALI DI CONTROLLO: sangue di controllo preparato con globuli rossi umani utilizzabile
Emissione 2 25/11/2011 Approvazione DCRB Pagina 1 di 7 PROGRAMMA DI VEQ PER VES A. Organizzazione del Programma MATERIALI DI CONTROLLO: sangue di controllo preparato con globuli rossi umani utilizzabile
ANALISI URINE UN ESAME DI QUALITÀ AL SERVIZIO DELLA CLINICA
 ANALISI UN ESAME DI QUALITÀ AL SERVIZIO DELLA CLINICA ANALISI UN ESAME DI QUALITÀ AL SERVIZIO DELLA CLINICA L analisi di qualità della matrice urinaria è fondamentale per la diagnosi precoce delle malattie
ANALISI UN ESAME DI QUALITÀ AL SERVIZIO DELLA CLINICA ANALISI UN ESAME DI QUALITÀ AL SERVIZIO DELLA CLINICA L analisi di qualità della matrice urinaria è fondamentale per la diagnosi precoce delle malattie
LEUCEMIA LINFATICA CRONICA
 LEUCEMIA LINFATICA CRONICA NEOPLASIE (SINDROMI) LINFOPROLIFERATIVE CRONICHE Le sindromi linfoproliferative croniche sono malattie monoclonali neoplastiche prevalenti nell adulto anziano caratterizzate
LEUCEMIA LINFATICA CRONICA NEOPLASIE (SINDROMI) LINFOPROLIFERATIVE CRONICHE Le sindromi linfoproliferative croniche sono malattie monoclonali neoplastiche prevalenti nell adulto anziano caratterizzate
EMATOLOGIA RISULTATI INTERVALLI DI RIFERIMENTO
 Data Prelievo 13-04-13 Num.185593 FRANCHI GIORGIO ID. Paziente 130413185593 TEAM ROSSETTI Data di Nascita 13-03-1966 Nel presente referto la firma autografa e' sostituita dall'indicazione a stampa del
Data Prelievo 13-04-13 Num.185593 FRANCHI GIORGIO ID. Paziente 130413185593 TEAM ROSSETTI Data di Nascita 13-03-1966 Nel presente referto la firma autografa e' sostituita dall'indicazione a stampa del
Vantaggi, Problemi e Trappole nell Osservazione Microscopica del Sangue Periferico. Barbara Bain
 Vantaggi, Problemi e Trappole nell Osservazione Microscopica del Sangue Periferico Barbara Bain Per studio personale Non può essere usato per altri scopi senza il permesso specifico I problemi possono
Vantaggi, Problemi e Trappole nell Osservazione Microscopica del Sangue Periferico Barbara Bain Per studio personale Non può essere usato per altri scopi senza il permesso specifico I problemi possono
mini-hta delle Tecnologie
 mini-hta delle Tecnologie DATI PRELIMINARI 1. Proponente Azienda Dipartimento- Struttura ASL 5 spezzino CAD, assistenza integrativa per diabetici 2. Identificazione della tecnologia proposta me, tipo,
mini-hta delle Tecnologie DATI PRELIMINARI 1. Proponente Azienda Dipartimento- Struttura ASL 5 spezzino CAD, assistenza integrativa per diabetici 2. Identificazione della tecnologia proposta me, tipo,
CICLO ANALITICO COMPLETO
 Trattamento Farmacologico Attività Fisica Dieta Ritmi Circadiani Richiesta del Test Paziente Postura Orario Materiale di Prelievo Prelievo Decisione Medica Valori decisionali (cut off points) Trattamento
Trattamento Farmacologico Attività Fisica Dieta Ritmi Circadiani Richiesta del Test Paziente Postura Orario Materiale di Prelievo Prelievo Decisione Medica Valori decisionali (cut off points) Trattamento
EMATOLOGIA: OBIETTIVI CLINICI E PERCORSI DIAGNOSTICI
 Corso di aggiornamento n. Rif. 61972 Provider n. 1218 EMATOLOGIA: OBIETTIVI CLINICI E PERCORSI DIAGNOSTICI Crediti formativi 26 Ai fini dell erogazione dei crediti è necessario seguire il 100% dell attività
Corso di aggiornamento n. Rif. 61972 Provider n. 1218 EMATOLOGIA: OBIETTIVI CLINICI E PERCORSI DIAGNOSTICI Crediti formativi 26 Ai fini dell erogazione dei crediti è necessario seguire il 100% dell attività
Possibilità terapeutiche attuali nelle sindromi mielodisplastiche
 Possibilità terapeutiche attuali nelle sindromi mielodisplastiche Luca Malcovati, Professore Associato di Ematologia, Dipartimento di Ematologia e Oncologia, Fondazione IRCCS Policlinico San Matteo & Dipartimento
Possibilità terapeutiche attuali nelle sindromi mielodisplastiche Luca Malcovati, Professore Associato di Ematologia, Dipartimento di Ematologia e Oncologia, Fondazione IRCCS Policlinico San Matteo & Dipartimento
Medical Systems. BC-6800 Analizzatore Automatico per Ematologia. Un piccolo cubo, una grande differenza
 Medical Systems BC-6800 Analizzatore Automatico per Ematologia Un piccolo cubo, una grande differenza La Differenza in un Piccolo Cubo 2D NEU EOS Luce scatterata Piccolo angolo MON LYM + Grande angolo
Medical Systems BC-6800 Analizzatore Automatico per Ematologia Un piccolo cubo, una grande differenza La Differenza in un Piccolo Cubo 2D NEU EOS Luce scatterata Piccolo angolo MON LYM + Grande angolo
SCHEMA DI VEQ PER VES FOTOMETRIA CAPILLARE QUANTITATIVA. Emissione 2 25/11/2011 Approvazione DCRB Pagina 1 di 6
 Emissione 2 25/11/2011 Approvazione DCRB Pagina 1 di 6 PROGRAMMA DI VEQ PER VES A. Organizzazione del Programma MATERIALI DI CONTROLLO: campioni di lattice pronti per l uso utilizzabili esclusivamente
Emissione 2 25/11/2011 Approvazione DCRB Pagina 1 di 6 PROGRAMMA DI VEQ PER VES A. Organizzazione del Programma MATERIALI DI CONTROLLO: campioni di lattice pronti per l uso utilizzabili esclusivamente
Informazioni sul corso ed eventuali diapositive delle lezioni:
 Informazioni sul corso ed eventuali diapositive delle lezioni: www.bioclinica.unipi.it http://arsdocendi.med.unipi.it Per qualsiasi comunicazione: [email protected] Per informazioni su appelli/iscrizione
Informazioni sul corso ed eventuali diapositive delle lezioni: www.bioclinica.unipi.it http://arsdocendi.med.unipi.it Per qualsiasi comunicazione: [email protected] Per informazioni su appelli/iscrizione
CAPITOLATO TECNICO. Service per la fornitura di strumenti e reattivi per il Settore Ematologia.
 AZIENDA OSPEDALIERO UNIVERSITARIA DI CAGLIARI U.O.S.C. Laboratorio Analisi Chimico Cliniche e Microbiologia PP.OO. S.Giovanni di Dio- Policlinico Monserrato Sede legale Via Ospedale 54-09124 Cagliari CAPITOLATO
AZIENDA OSPEDALIERO UNIVERSITARIA DI CAGLIARI U.O.S.C. Laboratorio Analisi Chimico Cliniche e Microbiologia PP.OO. S.Giovanni di Dio- Policlinico Monserrato Sede legale Via Ospedale 54-09124 Cagliari CAPITOLATO
La lettura dell emocromo: al di là dei numeri. Bruno Nobili. Dipartimento di Pediatria Seconda Università Napoli
 La lettura dell emocromo: al di là dei numeri Bruno Nobili Dipartimento di Pediatria Seconda Università Napoli Esame emocromocitometrico Esame di primo livello Orientarsi bene tra tante sigle e numeri
La lettura dell emocromo: al di là dei numeri Bruno Nobili Dipartimento di Pediatria Seconda Università Napoli Esame emocromocitometrico Esame di primo livello Orientarsi bene tra tante sigle e numeri
Applicazione di regole di validazione dell esame emocromocitometrico nel laboratorio analisi dell ospedale di Desio*
 Applicazione di regole di validazione dell esame emocromocitometrico nel laboratorio analisi dell ospedale di Desio* Adele Cappellani 1, Fabrizio Cappellini 1, Francesca Maria Biella 1, Flavia Sciarini
Applicazione di regole di validazione dell esame emocromocitometrico nel laboratorio analisi dell ospedale di Desio* Adele Cappellani 1, Fabrizio Cappellini 1, Francesca Maria Biella 1, Flavia Sciarini
INDICE. parte prima Allestimento ed interpretazione dei preparati
 INDICE parte prima Allestimento ed interpretazione dei preparati capitolo 1 Generalità Prelievo del campione Preparazione dello striscio Colorazione degli strisci Cause di colorazioni anomale di più frequente
INDICE parte prima Allestimento ed interpretazione dei preparati capitolo 1 Generalità Prelievo del campione Preparazione dello striscio Colorazione degli strisci Cause di colorazioni anomale di più frequente
SINDROME DI BERNARD-SOULIER. STUDIO CLINICO-EMATOLOGICO E ULTRASTRUTTURALE DI UN CASO.
 SINDROME DI BERNARD-SOULIER. STUDIO CLINICO-EMATOLOGICO E ULTRASTRUTTURALE DI UN CASO. Introduzione. I disordini ereditari delle piastrine giganti sono classicamente suddivisi in 4 gruppi: quello con alterazioni
SINDROME DI BERNARD-SOULIER. STUDIO CLINICO-EMATOLOGICO E ULTRASTRUTTURALE DI UN CASO. Introduzione. I disordini ereditari delle piastrine giganti sono classicamente suddivisi in 4 gruppi: quello con alterazioni
SINDROME DA ANTICORPI ANTI-FOSFOLIPIDI
 SINDROME DA ANTICORPI ANTI-FOSFOLIPIDI Malattia caratterizzata da trombosi arteriose e/o venose ricorrenti, aborti ripetuti, trombocitopenia,, in associazione a titoli medio-alti di anticorpi anti-fosfolipidi
SINDROME DA ANTICORPI ANTI-FOSFOLIPIDI Malattia caratterizzata da trombosi arteriose e/o venose ricorrenti, aborti ripetuti, trombocitopenia,, in associazione a titoli medio-alti di anticorpi anti-fosfolipidi
SPECIFICHE TECNICHE E ORGANIZZATIVE LOTTO UNICO EMATOLOGIA COAGULAZIONE VES EMOGLOBINE GLICATE
 1 ALLEGATO A) SPECIFICHE TECNICHE E ORGANIZZATIVE LOTTO UNICO EMATOLOGIA COAGULAZIONE VES EMOGLOBINE GLICATE SI RICHIEDE OFFERTA PER SISTEMI ANALITICI, DI ULTIMA GENERAZIONE, COMPLETAMENTE AUTOMATICI,
1 ALLEGATO A) SPECIFICHE TECNICHE E ORGANIZZATIVE LOTTO UNICO EMATOLOGIA COAGULAZIONE VES EMOGLOBINE GLICATE SI RICHIEDE OFFERTA PER SISTEMI ANALITICI, DI ULTIMA GENERAZIONE, COMPLETAMENTE AUTOMATICI,
Sangue. Created by G. Papaccio 1
 Sangue Created by G. Papaccio 1 Sangue Tessuto connettivo a carattere fluido che scorre in un sistema di canali comunicanti (vasi arteriosi e venosi) Composto da una parte fluida e da cellule definite
Sangue Created by G. Papaccio 1 Sangue Tessuto connettivo a carattere fluido che scorre in un sistema di canali comunicanti (vasi arteriosi e venosi) Composto da una parte fluida e da cellule definite
Le certezze e i dubbi del medico d urgenza
 GESTIONE IN DEA DEL PAZIENTE CON DOLORE ADDOMINALE Torino, 20 febbraio 2010 Azienda Ospedaliera Ordine Mauriziano Le certezze e i dubbi del medico d urgenza Luisa Arnaldi SC Medicina d Urgenza Ospedale
GESTIONE IN DEA DEL PAZIENTE CON DOLORE ADDOMINALE Torino, 20 febbraio 2010 Azienda Ospedaliera Ordine Mauriziano Le certezze e i dubbi del medico d urgenza Luisa Arnaldi SC Medicina d Urgenza Ospedale
Il Contenuto Emoglobinico reticolocitario (CHr) Indicatore precoce della carenza di ferro e della risposta alla terapia marziale
 Il Contenuto Emoglobinico reticolocitario (CHr) Indicatore precoce della carenza di ferro e della risposta alla terapia marziale Stefano Costantini, Valerio Maria Bonavia Viterbo, I Dicembre 2005 Incidenza
Il Contenuto Emoglobinico reticolocitario (CHr) Indicatore precoce della carenza di ferro e della risposta alla terapia marziale Stefano Costantini, Valerio Maria Bonavia Viterbo, I Dicembre 2005 Incidenza
VALORI o LIVELLI DECISIONALI
 In alternativa all intervallo di riferimento VALORI o LIVELLI DECISIONALI Valori sopra o sotto i quali è raccomandabile seguire un determinato comportamento clinico: - Instaurare o modificare un regime
In alternativa all intervallo di riferimento VALORI o LIVELLI DECISIONALI Valori sopra o sotto i quali è raccomandabile seguire un determinato comportamento clinico: - Instaurare o modificare un regime
CASO CLINICO: UOMO DI 48 ANNI 29/08/2014 PRONTO SOCCORSO FEBBRE
 CASO CLINICO: UOMO DI 48 ANNI 29/08/2014 PRONTO SOCCORSO FEBBRE 28/08/2014 WBC: 10.43 x10^9/l RBC: 2.73 x10^12/l HB : 89 x10^9/l MCV: 95,MCH:32.6,MCHC:344 PLT: 117 x10^9/l LUC: 1.29 x10^9/l ALLARME ADVIA:MDS
CASO CLINICO: UOMO DI 48 ANNI 29/08/2014 PRONTO SOCCORSO FEBBRE 28/08/2014 WBC: 10.43 x10^9/l RBC: 2.73 x10^12/l HB : 89 x10^9/l MCV: 95,MCH:32.6,MCHC:344 PLT: 117 x10^9/l LUC: 1.29 x10^9/l ALLARME ADVIA:MDS
UF-1000i. L evoluzione nella diagnostica del profilo urinario
 UF-1000i L evoluzione nella diagnostica del profilo urinario Sysmex UF-1000i Il progresso della citometria a flusso in fluorescenza Da oltre 15 anni Sysmex propone al laboratorio nuovi metodi diagnostici
UF-1000i L evoluzione nella diagnostica del profilo urinario Sysmex UF-1000i Il progresso della citometria a flusso in fluorescenza Da oltre 15 anni Sysmex propone al laboratorio nuovi metodi diagnostici
CAPITOLATO TECNICO LOTTO n. 7 test di ematologia
 GARA D APPALTO TELEMATICA, A PROCEDURA APERTA, PER LA FORNITURA IN SERVICE DI SISTEMI DIAGSTICI PER LA MEDICINA DI LABORATORIO DELL AZIENDA N. 17. CAPITOLATO TECNICO LOTTO n. 7 test di ematologia ART.
GARA D APPALTO TELEMATICA, A PROCEDURA APERTA, PER LA FORNITURA IN SERVICE DI SISTEMI DIAGSTICI PER LA MEDICINA DI LABORATORIO DELL AZIENDA N. 17. CAPITOLATO TECNICO LOTTO n. 7 test di ematologia ART.
Linfoma di Hodgkin (LH) Criticità della registrazione
 corso per operatori dei Registri Tumori AIRTUM I TUMORI EMATOLOGICI criticità nella diagnosi, registrazione e classificazione Linfoma di Hodgkin (LH) Criticità della registrazione Simona Nuzzo Registro
corso per operatori dei Registri Tumori AIRTUM I TUMORI EMATOLOGICI criticità nella diagnosi, registrazione e classificazione Linfoma di Hodgkin (LH) Criticità della registrazione Simona Nuzzo Registro
SCHEMA DI VEQ PER EMATOLOGIA. Emissione 8 01/09/2015 Approvazione DCRB Page 1 of 5
 Emissione 8 01/09/2015 Approvazione DCRB Page 1 of 5 PROGRAMMA DI VEQ PER EMATOLOGIA A. Organizzazione del Programma MATERIALI DI CONTROLLO: sangue di controllo contenente leucociti umani, eritrociti umani
Emissione 8 01/09/2015 Approvazione DCRB Page 1 of 5 PROGRAMMA DI VEQ PER EMATOLOGIA A. Organizzazione del Programma MATERIALI DI CONTROLLO: sangue di controllo contenente leucociti umani, eritrociti umani
INQUADRAMENTO DIAGNOSTICO DELLE LESIONI GHIANDOLARI: DIFFERENZE MORFOLOGICHE IN CITOLOGIA CONVENZIONALE E IN FASE LIQUIDA
 WORKSHOP PRECONGRESSUALE GISCi Centro Direzionale di Napoli, Università Parthenope MERCOLEDI, 8 GIUGNO 2016 INQUADRAMENTO DIAGNOSTICO DELLE LESIONI GHIANDOLARI: DIFFERENZE MORFOLOGICHE IN CITOLOGIA CONVENZIONALE
WORKSHOP PRECONGRESSUALE GISCi Centro Direzionale di Napoli, Università Parthenope MERCOLEDI, 8 GIUGNO 2016 INQUADRAMENTO DIAGNOSTICO DELLE LESIONI GHIANDOLARI: DIFFERENZE MORFOLOGICHE IN CITOLOGIA CONVENZIONALE
DIAGNOSI di LABORATORIO dell' INFEZIONE da HIV :
 Pievesestina di Cesena - 29 febbraio 2012 DIAGNOSI di LABORATORIO dell' INFEZIONE da HIV : il percorso analitico in Area Vasta Romagna Simona Semprini. U.O. Microbiologia - Laboratorio Unico AVR Human
Pievesestina di Cesena - 29 febbraio 2012 DIAGNOSI di LABORATORIO dell' INFEZIONE da HIV : il percorso analitico in Area Vasta Romagna Simona Semprini. U.O. Microbiologia - Laboratorio Unico AVR Human
ESAME RISULTATO INTERVALLO DI RIFERIMENTO* PT 7.6 (<25%C) 4-10" 4-10" APTT 14.2 (<25%C) 4,5-25" 4,5-25" Fibrinogeno 280 mg/dl ATIII
 Proprietario: Meticcio Veterinario: Dr Cocca Nome: Specie: razza: Pointer Età: 1a Sesso: maschio Data: 18/06/10 PROFILO COAGULATIVO PT 7.6 (
Proprietario: Meticcio Veterinario: Dr Cocca Nome: Specie: razza: Pointer Età: 1a Sesso: maschio Data: 18/06/10 PROFILO COAGULATIVO PT 7.6 (
Qualificazione del personale addetto alla raccolta del sangue e degli emocomponenti. La determinazione dell emoglobina e/o. emocromocitometrico
 Qualificazione del personale addetto alla raccolta del sangue e degli emocomponenti La determinazione dell emoglobina e/o l esecuzione lesecuzione dell esame esame emocromocitometrico FINALITÀ DELL ESAME
Qualificazione del personale addetto alla raccolta del sangue e degli emocomponenti La determinazione dell emoglobina e/o l esecuzione lesecuzione dell esame esame emocromocitometrico FINALITÀ DELL ESAME
LE SINDROMI MIELODISPLASTICHE. Sono disordini acquisiti clonali delle cellule staminali emopoietiche
 LE SINDROMI MIELODISPLASTICHE Sono disordini acquisiti clonali delle cellule staminali emopoietiche EMOPOIESI INEFFICACE (midollo ipercellulare) ANEMIA e/o NEUTROPENIA e/o PIASTRINOPENIA EVOLUZIONE IN
LE SINDROMI MIELODISPLASTICHE Sono disordini acquisiti clonali delle cellule staminali emopoietiche EMOPOIESI INEFFICACE (midollo ipercellulare) ANEMIA e/o NEUTROPENIA e/o PIASTRINOPENIA EVOLUZIONE IN
Ospedale Ca Foncello di Treviso. Anatomia Patologica. Guida ai Servizi
 Ospedale Ca Foncello di Treviso Anatomia Patologica Guida ai Servizi L Unità Operativa Complessa di Anatomia Patologica effettua indagini di laboratorio su campioni di diversa tipologia con lo scopo di
Ospedale Ca Foncello di Treviso Anatomia Patologica Guida ai Servizi L Unità Operativa Complessa di Anatomia Patologica effettua indagini di laboratorio su campioni di diversa tipologia con lo scopo di
Policlinico di Monza Istituto ad Alta Specializzazione NEVI E CAPELLI. La tecnologia VIDIX VTRACK a servizio del dermatologo
 Policlinico di Monza Istituto ad Alta Specializzazione NEVI E CAPELLI La tecnologia VIDIX VTRACK a servizio del dermatologo INTRODUZIONE Da diversi anni si registra l'aumento dei casi di melanoma, un tumore
Policlinico di Monza Istituto ad Alta Specializzazione NEVI E CAPELLI La tecnologia VIDIX VTRACK a servizio del dermatologo INTRODUZIONE Da diversi anni si registra l'aumento dei casi di melanoma, un tumore
Serie XN-L. La Serie XN-L. Nuove prospettive in Ematologia. Caratteristiche XN-350 XN-450 XN-550
 in ematologia. Serie XN-L La Serie XN-L Nuove prospettive in Ematologia Caratteristiche XN-350 Cadenza analitica fino a 60 campioni/h in modalità sangue intero (WB) fino a 70 campioni/h in modalità WB
in ematologia. Serie XN-L La Serie XN-L Nuove prospettive in Ematologia Caratteristiche XN-350 Cadenza analitica fino a 60 campioni/h in modalità sangue intero (WB) fino a 70 campioni/h in modalità WB
Valutazione del sistema Cellavision DM-96 nell analisi della formula leucocitaria e nel conteggio piastrinico
 DOI 10.1007/s13631-015-0085-3 ARTICOLO ORIGINALE Valutazione del sistema Cellavision DM-96 nell analisi della formula leucocitaria e nel conteggio piastrinico Cellavision DM-96: white blood cell morphological
DOI 10.1007/s13631-015-0085-3 ARTICOLO ORIGINALE Valutazione del sistema Cellavision DM-96 nell analisi della formula leucocitaria e nel conteggio piastrinico Cellavision DM-96: white blood cell morphological
INTRODUZIONE: L introduzione della citologia per aspirazione con ago sottile ha rappresentato un
 INTRODUZIONE: L introduzione della citologia per aspirazione con ago sottile ha rappresentato un notevole progresso nella diagnostica delle lesioni tiroidee. Infatti, benché le innovazioni tecnologiche
INTRODUZIONE: L introduzione della citologia per aspirazione con ago sottile ha rappresentato un notevole progresso nella diagnostica delle lesioni tiroidee. Infatti, benché le innovazioni tecnologiche
AZIENDA OSPEDALIERA VILLA SOFIA CERVELLO PALERMO. Procedura aperta affidamento quinquennale sistemi diagnostici N. gara
 AZIENDA OSPEDALIERA VILLA SOFIA CERVELLO PALERMO Procedura aperta affidamento quinquennale sistemi diagnostici N. gara 5978303 CHIARIMENTI del 23.6.2015 Si precisa che dal lotto 10 viene annullato quanto
AZIENDA OSPEDALIERA VILLA SOFIA CERVELLO PALERMO Procedura aperta affidamento quinquennale sistemi diagnostici N. gara 5978303 CHIARIMENTI del 23.6.2015 Si precisa che dal lotto 10 viene annullato quanto
DM 2 NOVEMBRE 2015 ESAMI OBBLIGATORI AD OGNI DONAZIONE E CONTROLLI PERIODICI
 DM 2 NOVEMBRE 2015 ESAMI OBBLIGATORI AD OGNI DONAZIONE E CONTROLLI PERIODICI Art. 10 Validazione biologica delle unità di sangue ed emocomponenti 1. Ad ogni donazione il donatore viene obbligatoriamente
DM 2 NOVEMBRE 2015 ESAMI OBBLIGATORI AD OGNI DONAZIONE E CONTROLLI PERIODICI Art. 10 Validazione biologica delle unità di sangue ed emocomponenti 1. Ad ogni donazione il donatore viene obbligatoriamente
ANALIZZATORI EMATOLOGICI Coulter HmX Autoloader
 ANALIZZATORI EMATOLOGICI Coulter HmX Autoloader CARATTERISTICHE GENERALI Il Coulter Hmx con Autoloader (autocampionatore) è un analizzatore ematologico automatico per uso diagnostico in vitro. E in grado
ANALIZZATORI EMATOLOGICI Coulter HmX Autoloader CARATTERISTICHE GENERALI Il Coulter Hmx con Autoloader (autocampionatore) è un analizzatore ematologico automatico per uso diagnostico in vitro. E in grado
Cos è. una leucemia. bianche all interno. del midollo osseo. E di natura clonale. secondario ad altri stimoli
 Le leucemie Cos è una leucemia Una proliferazione anomala delle cellule ematiche bianche all interno del midollo osseo. E di natura clonale (in genere interessa una singola linea cellulare) Può insorgere
Le leucemie Cos è una leucemia Una proliferazione anomala delle cellule ematiche bianche all interno del midollo osseo. E di natura clonale (in genere interessa una singola linea cellulare) Può insorgere
Tab. VII - Protocollo per le indagini di laboratorio e strumentali consigliate nella gravidanza fisiologica
 Per gli esami di laboratorio, presentiamo il protocollo della regione Toscana (Tab. VII) per vedere se c'è stato un adeguamento alla gravidanza (Tab. VIII); i segni della emodiluizione dovrebbero essere
Per gli esami di laboratorio, presentiamo il protocollo della regione Toscana (Tab. VII) per vedere se c'è stato un adeguamento alla gravidanza (Tab. VIII); i segni della emodiluizione dovrebbero essere
Linee guida per il referto ematologico
 Linee guida per il referto ematologico P. Cappelletti Laboratorio di Patologia Clinica, Dipartimento di Medicina di Laboratorio, Azienda Ospedaliera S. Maria degli Angeli di Pordenone GdSE-SIMeL P. Cappelletti
Linee guida per il referto ematologico P. Cappelletti Laboratorio di Patologia Clinica, Dipartimento di Medicina di Laboratorio, Azienda Ospedaliera S. Maria degli Angeli di Pordenone GdSE-SIMeL P. Cappelletti
Seconda Università di Napoli Dipartimento di Pediatria F. Fede
 Seconda Università di Napoli Dipartimento di Pediatria F. Fede FIMPAGGIORNA 2005 Bruno Nobili La lettura dell esame emocromocitometrico Caserta 12 maggio 2005 L osservazione che il sangue è in parte costituito
Seconda Università di Napoli Dipartimento di Pediatria F. Fede FIMPAGGIORNA 2005 Bruno Nobili La lettura dell esame emocromocitometrico Caserta 12 maggio 2005 L osservazione che il sangue è in parte costituito
MORFOLOGIA DEL SANGUE MIDOLLARE E PERIFERICO: STANDARD, QUALITÀ E REFERTO
 Società Italiana di Biochimica Clinica e Biologia Molecolare Clinica SIBioC utlizza un Sistema di Gestione Qualità certificato ISO 9001:2008 per progettazione ed erogazione di eventi formativi MORFOLOGIA
Società Italiana di Biochimica Clinica e Biologia Molecolare Clinica SIBioC utlizza un Sistema di Gestione Qualità certificato ISO 9001:2008 per progettazione ed erogazione di eventi formativi MORFOLOGIA
SANGUE FASE LIQUIDA PLASMA SOLUZIONE SALI MINERALI E ORGANICI
 Il sangue SANGUE SANGUE : SISTEMA BIFASICO FASE LIQUIDA PLASMA SOLUZIONE SALI MINERALI E ORGANICI FASE SOLIDA CELLULE NUCLEATE (g. bianchi) CELLULE ANUCLEATE (g. rossi) FRAMMENTI CITOPLASMATICI (piastrine)
Il sangue SANGUE SANGUE : SISTEMA BIFASICO FASE LIQUIDA PLASMA SOLUZIONE SALI MINERALI E ORGANICI FASE SOLIDA CELLULE NUCLEATE (g. bianchi) CELLULE ANUCLEATE (g. rossi) FRAMMENTI CITOPLASMATICI (piastrine)
Ipereosinofilie e Mastocitosi: problematiche cliniche
 Prima Giornata Fiorentina dedicata ai pazienti con malattie mieloproliferative croniche Venerdì 15 aprile 2011 Ipereosinofilie e Mastocitosi: problematiche cliniche Lisa Pieri Università degli Studi di
Prima Giornata Fiorentina dedicata ai pazienti con malattie mieloproliferative croniche Venerdì 15 aprile 2011 Ipereosinofilie e Mastocitosi: problematiche cliniche Lisa Pieri Università degli Studi di
DESCRIZIONE DELLA FORNITURA
 ALLEGATO 1 DESCRIZIONE DELLA FORNITURA PROCEDURA APERTA PER LA FORNITURA DI SISTEMI ANALITICI COMPRENDENTI STRUMENTAZIONE, REAGENTI E MATERIALE DI CONSUMO PER L INDAGINE DIAGNOSTICA DI EMOCROMOCITOMETRIA,
ALLEGATO 1 DESCRIZIONE DELLA FORNITURA PROCEDURA APERTA PER LA FORNITURA DI SISTEMI ANALITICI COMPRENDENTI STRUMENTAZIONE, REAGENTI E MATERIALE DI CONSUMO PER L INDAGINE DIAGNOSTICA DI EMOCROMOCITOMETRIA,
Valutazione del test rapido Geenius HIV1/2 per la conferma degli anticorpi anti HIV1-2. Gianna Mazzarelli
 Valutazione del test rapido Geenius HIV1/2 per la conferma degli anticorpi anti HIV1-2 Gianna Mazzarelli 14/09/2015 Tempi di rilevazione di specifici markers di infezione HIV Test combinati Ag/Ab Ag ricombinanti
Valutazione del test rapido Geenius HIV1/2 per la conferma degli anticorpi anti HIV1-2 Gianna Mazzarelli 14/09/2015 Tempi di rilevazione di specifici markers di infezione HIV Test combinati Ag/Ab Ag ricombinanti
Pentra DX Nexus. Process efficiency in Hematology
 Pentra DX Nexus Process efficiency in Hematology Pentra DX Nexus Alte performance di qualità, produttività e flessibilità 120 campioni per ora 50 parametri Reflex test automatico Validazione automatica
Pentra DX Nexus Process efficiency in Hematology Pentra DX Nexus Alte performance di qualità, produttività e flessibilità 120 campioni per ora 50 parametri Reflex test automatico Validazione automatica
ISTOLOGIA E CITOLOGIA PATOLOGICA VETERINARIA
 CORSO DI ISTOLOGIA E CITOLOGIA PATOLOGICA VETERINARIA Insegnamento del Corso integrato di Anatomia Patologica Veterinaria Docente P. Maiolino E-mail: [email protected] -Dipartimento di Patologia e Sanità
CORSO DI ISTOLOGIA E CITOLOGIA PATOLOGICA VETERINARIA Insegnamento del Corso integrato di Anatomia Patologica Veterinaria Docente P. Maiolino E-mail: [email protected] -Dipartimento di Patologia e Sanità
Azienda Ospedaliero Universitaria Careggi
 Azienda Ospedaliero Universitaria Careggi Laboratorio Generale Centro Regionale di Riferimento per il Controllo di Qualità AOU Careggi - Firenze Stato dell Arte dei Dosaggi della HbA 1C Anna Caldini 1
Azienda Ospedaliero Universitaria Careggi Laboratorio Generale Centro Regionale di Riferimento per il Controllo di Qualità AOU Careggi - Firenze Stato dell Arte dei Dosaggi della HbA 1C Anna Caldini 1
LEUCEMIE MIELOIDI CRONICHE
 LEUCEMIE MIELOIDI CRONICHE La Leucemia Mieloide Cronica (LMC) è una malattia neoplastica relativamente rara (1-2 casi/100.000 abitanti/anno) prevalente nell adulto-anziano. Le cellule leucemiche sono caratterizzate
LEUCEMIE MIELOIDI CRONICHE La Leucemia Mieloide Cronica (LMC) è una malattia neoplastica relativamente rara (1-2 casi/100.000 abitanti/anno) prevalente nell adulto-anziano. Le cellule leucemiche sono caratterizzate
LM-41 Medicina e Chirurgia Hypatìa Sede formativa di Caltanissetta CORSO INTEGRATO
 FACOLTÀ MEDICINA E CHIRURGIA ANNO ACCADEMICO 0/03 CORSO DI LAUREA (o LAUREA MAGISTRALE) LM-4 Medicina e Chirurgia Hypatìa Sede formativa di Caltanissetta CORSO INTEGRATO MEDICINA DI LABORATORIO TIPO DI
FACOLTÀ MEDICINA E CHIRURGIA ANNO ACCADEMICO 0/03 CORSO DI LAUREA (o LAUREA MAGISTRALE) LM-4 Medicina e Chirurgia Hypatìa Sede formativa di Caltanissetta CORSO INTEGRATO MEDICINA DI LABORATORIO TIPO DI
Urilyzer. Duo. Porta a un nuovo livello la diagnosi urinaria
 Urilyzer Duo Porta a un nuovo livello la diagnosi urinaria Prestazioni affidabili Facilità d uso Funzionamento efficiente in termini di costi Assistenza professionale Urilyzer Duo www.analyticon-diagnostics.com
Urilyzer Duo Porta a un nuovo livello la diagnosi urinaria Prestazioni affidabili Facilità d uso Funzionamento efficiente in termini di costi Assistenza professionale Urilyzer Duo www.analyticon-diagnostics.com
ALLEGATO A DEL CAPITOLATO SPECIALE DI FORNITURA
 ALLEGATO A DEL CAPITOLATO SPECIALE DI FORNITURA FORNITURA DI SISTEMI ANALITICI COMPLETI PER L ESECUZIONE DI ESAMI EMATOLOGICI OCCORRENTI ALL AZIENDA OSPEDALIERA CARLO POMA DI MANTOVA (CAPOFILA), ALL AZIENDA
ALLEGATO A DEL CAPITOLATO SPECIALE DI FORNITURA FORNITURA DI SISTEMI ANALITICI COMPLETI PER L ESECUZIONE DI ESAMI EMATOLOGICI OCCORRENTI ALL AZIENDA OSPEDALIERA CARLO POMA DI MANTOVA (CAPOFILA), ALL AZIENDA
Agoaspirato midollare e Biopsia osteomidollare. Carla Giordano
 Agoaspirato midollare e Biopsia osteomidollare Carla Giordano EMOPOIESI III settimana di sviluppo embrionale: sacco vitellino III mese di sviluppo : alcune cellule emopoietiche migrano nel fegato V mese
Agoaspirato midollare e Biopsia osteomidollare Carla Giordano EMOPOIESI III settimana di sviluppo embrionale: sacco vitellino III mese di sviluppo : alcune cellule emopoietiche migrano nel fegato V mese
astenia (causata dall anemia), aumentata suscettibilità alle infezioni (causata dalla leucopenia), emorragie (causate dalla piastinopenia).
 MIELODISPLASIE Le sindromi mielodisplastiche (SMD) sono un gruppo eterogeneo di malattie, prevalenti nell adulto-anziano, caratterizzate da una difettosa produzione, da parte del midollo osseo, di globuli
MIELODISPLASIE Le sindromi mielodisplastiche (SMD) sono un gruppo eterogeneo di malattie, prevalenti nell adulto-anziano, caratterizzate da una difettosa produzione, da parte del midollo osseo, di globuli
Il calcolo dei costi assistenziali del nuovo modello organizzativo
 Il calcolo dei costi assistenziali del nuovo modello organizzativo Marisa De Rosa 1 Congresso Nazionale SIFaCT Milano, 13 settembre 2013 CORE H24 per il riordino dell assistenza territoriale E un progetto
Il calcolo dei costi assistenziali del nuovo modello organizzativo Marisa De Rosa 1 Congresso Nazionale SIFaCT Milano, 13 settembre 2013 CORE H24 per il riordino dell assistenza territoriale E un progetto
Endocrinologia e laboratorio: quali informazioni dagli esami più frequenti
 Endocrinologia e laboratorio: quali informazioni dagli esami più frequenti Dr. Stefano Merlo, MS cardiol. PSV, ProntoSoccorsoVeterinario, Pinerolo (TO) Curva glicemica Curva glicemica Utilità, metodica,
Endocrinologia e laboratorio: quali informazioni dagli esami più frequenti Dr. Stefano Merlo, MS cardiol. PSV, ProntoSoccorsoVeterinario, Pinerolo (TO) Curva glicemica Curva glicemica Utilità, metodica,
I RETICOLOCITI M. BUTTARELLO ULSS 19 ADRIA (RO)
 I RETICOLOCITI M. BUTTARELLO ULSS 19 ADRIA (RO) RETICOLOCITI: DEFINIZIONE (CLSI H44-A2) - CELLULE ERITROIDI DI TRANSIZIONE FRA IL PRECURSORE NUCLEATO E L ERITROCITA MATURO - DEFINIZIONE MICROSCOPICA: CELLULE
I RETICOLOCITI M. BUTTARELLO ULSS 19 ADRIA (RO) RETICOLOCITI: DEFINIZIONE (CLSI H44-A2) - CELLULE ERITROIDI DI TRANSIZIONE FRA IL PRECURSORE NUCLEATO E L ERITROCITA MATURO - DEFINIZIONE MICROSCOPICA: CELLULE
automazione: l evoluzione della professione del Tecnico Sanitario di Laboratorio Biomedico
 Dalla manualità all automazione: automazione: l evoluzione della professione del Tecnico Sanitario di Laboratorio Biomedico TSLB Roberta Prampolini LACC Dipartimento di Patologia Clinica 1 PERCORSO FORMATIVO:
Dalla manualità all automazione: automazione: l evoluzione della professione del Tecnico Sanitario di Laboratorio Biomedico TSLB Roberta Prampolini LACC Dipartimento di Patologia Clinica 1 PERCORSO FORMATIVO:
Ho pensato di raccogliere in modo organico e chiaro tutte le informazioni pratiche relative alla gravidanza. Mi sono basata sulle emozioni, i dubbi e
 Ho pensato di raccogliere in modo organico e chiaro tutte le informazioni pratiche relative alla gravidanza. Mi sono basata sulle emozioni, i dubbi e gli interrogativi che le future mamme ci hanno espresso
Ho pensato di raccogliere in modo organico e chiaro tutte le informazioni pratiche relative alla gravidanza. Mi sono basata sulle emozioni, i dubbi e gli interrogativi che le future mamme ci hanno espresso
